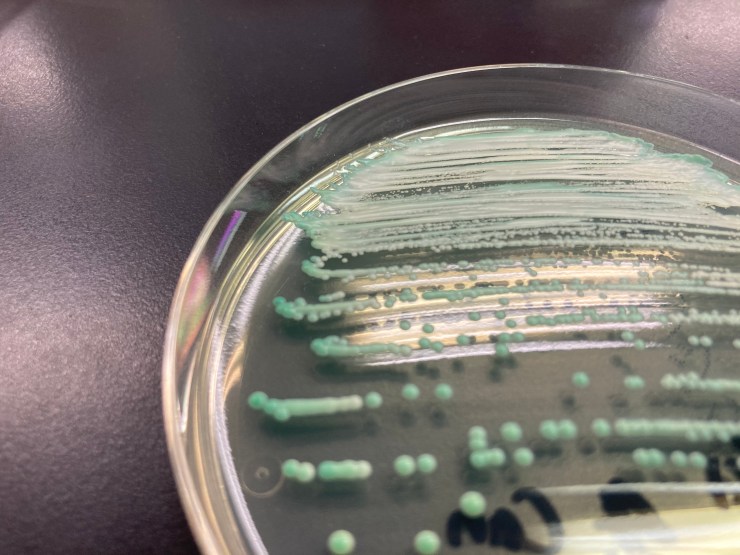
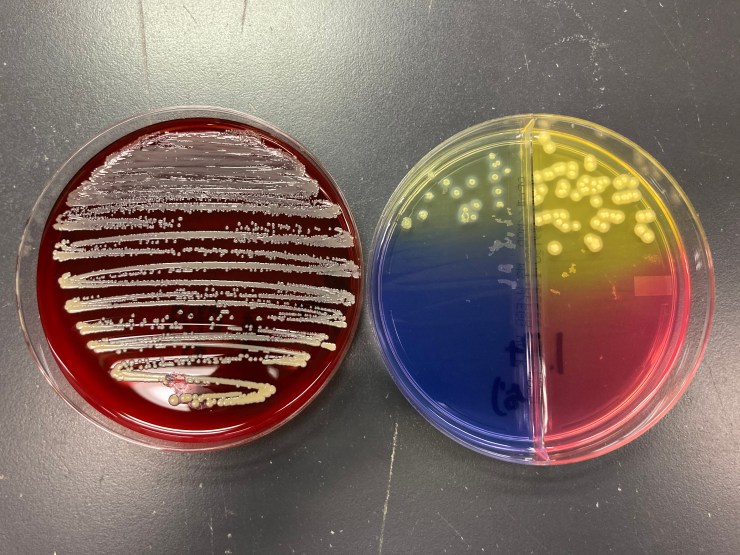

細菌検査室とは
細菌というと「汚い」とか「危険」などというイメージをされがちですが、 私たちの体には無数の常在菌が生息しています。 たとえば、皮膚だと1cm2あたり1000~10000個で、多いところでは10万個くらいみられ、 口腔内の歯垢では1mgあたり1000万個以上いるとされます。
また大腸内には100菌種以上合計100兆個もの細菌が生息しています。
私たちはこういった常在菌によって、病原性をもった細菌が外から侵入、定着しないように守られています。
普段の生活の中で、熱が出たり、発疹がでたり、下痢をしたりするのは、外から有害な細菌が侵入してきた、 もしくは常在菌中のバランスが崩れることにより病原性をもった菌が急に増加することによって、引き起こされます。


当院の細菌検査室は、そういった患者さんからでた検体を培養し、感染症の原因と思われる菌の菌種を同定し、 その菌に効く薬剤は何かということを詳しく調べます。 検体は、喀痰、尿、便、血液などをはじめ、ありとあらゆるものを検体として扱っております。
また、当院はMALDI Biotyper(質量分析装置)を導入しております。細菌のタンパク質を分析し菌名を迅速に確認し、菌血症など早急に対応しなければいけない場面で活躍しています。
当検査室は細菌(生き物)を相手にしているので、365日体制で細菌の培養を行い、結果を医師に報告しております。